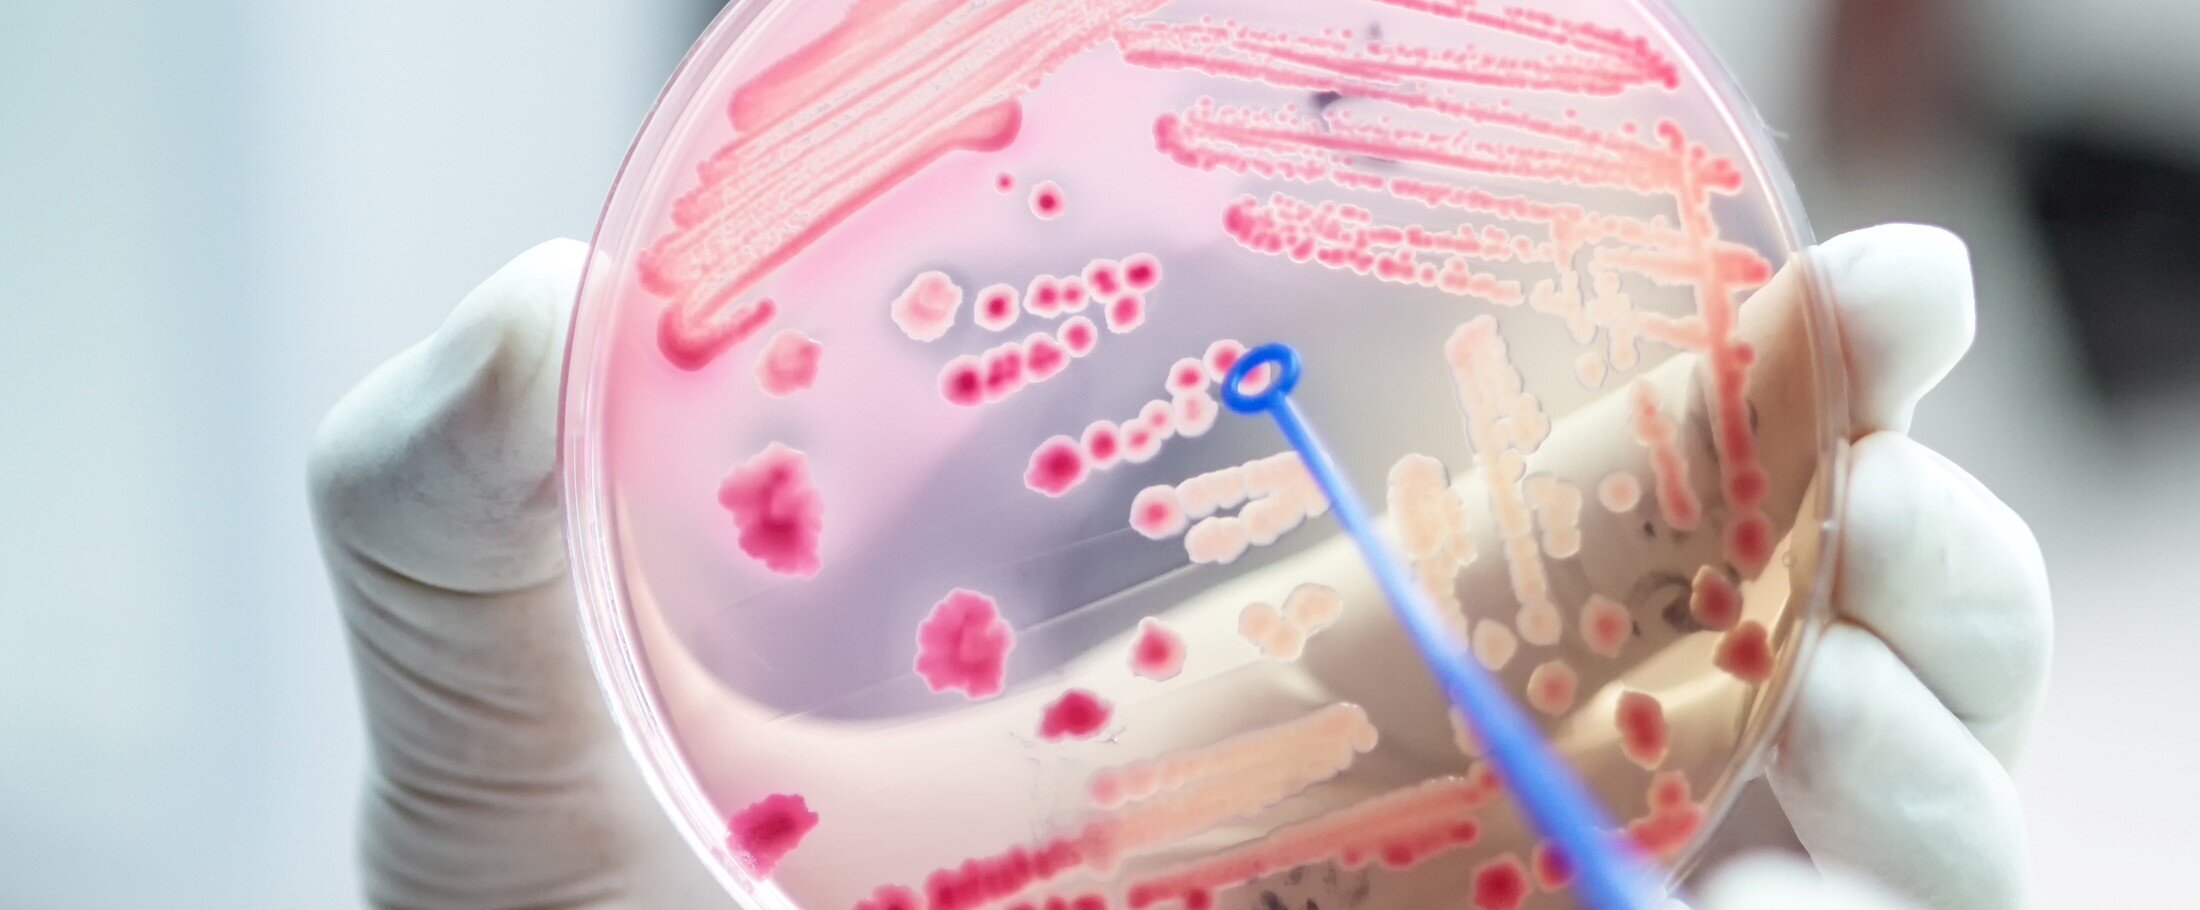
BRMO in de thuiszorg.jpeg

Het ROC van Twente heeft een modulereeks Wijkgericht Werken gemaakt, met maar liefst 7 modules. Door het volgen van deze modules kom je erachter wat wijkgericht werken inhoudt, de verschillende methodieken, kom je meer te weten over hulpvragers en begeleiders. De modules laten zien dat we allemaal deel zijn van een samenleving en je misschien alleen woont, maar nooit alleen leeft!
Ben je benieuwd geworden naar deze modules? Via onderstaande links kun je direct aan de slag: